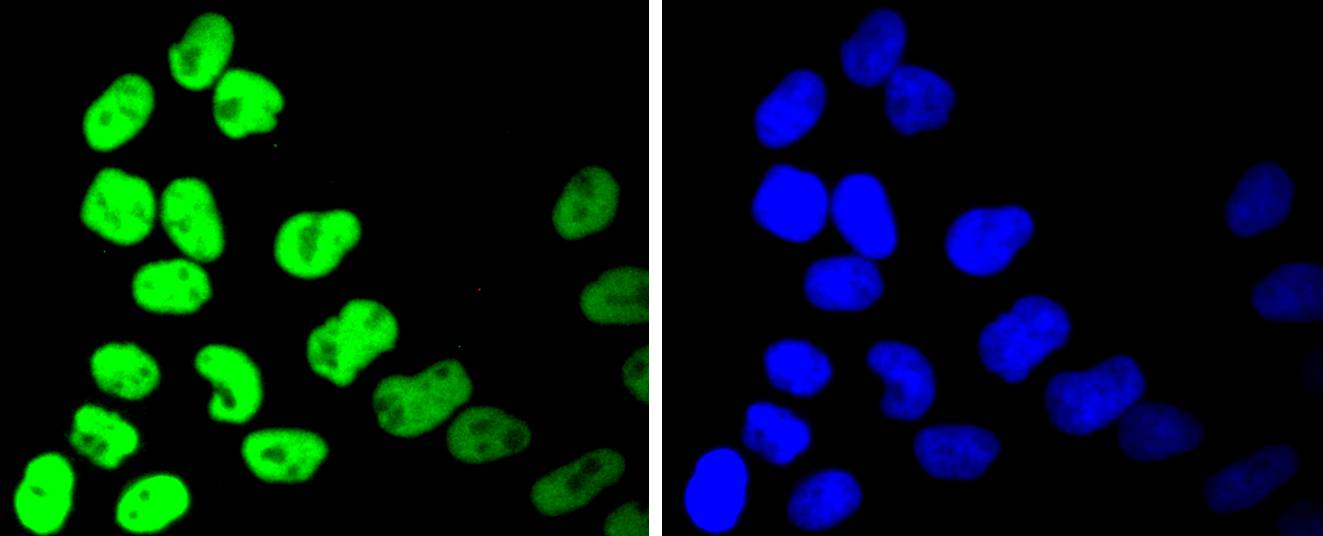
产品细节图片6

相关产品推荐更多 >
万千商家帮你免费找货
0 人在求购买到急需产品
- 详细信息
- 文献和实验
- 技术资料
- 免疫原:
recombinant protein
- 形态:
liquid
- 保存条件:
Store at -20˚C
- 克隆性:
Monoclonal antibody
- 适应物种:
Human;Mouse;Rat
- 保质期:
12 months
- 抗原来源:
Recombinant Rabbit
- 供应商:
南京赛戈巍生物科技有限公司
- 宿主:
Recombinant Rabbit
- 应用范围:
WB, ICC/IF, IHC, FC
- 靶点:
Uniprot:Q92769
- 抗体英文名:
HDAC2 Rabbit mAb
- 规格:
50ul/100ul
HD 2 antibody
HD2 antibody
HDAC 2 antibody
Hdac2 antibody
HDAC2_HUMAN antibody
Histone deacetylase 2 (HD2) antibody
Histone deacetylase 2 antibody
OTTHUMP00000017046 antibody
OTTHUMP00000227077 antibody
OTTHUMP00000227078 antibody
RPD3 antibody
transcriptional regulator homolog RPD3 antibody
YAF1 antibody
YY1 associated factor 1 antibody
YY1 transcription factor binding protein antibody
Yy1bp antibody
计算分子量:55 kDa
配方:1*TBS (pH7.4), 1%BSA, 40%Glycerol. Preservative: 0.05% Sodium Azide.
应用详情:WB: 1:1,000-1:2,000
IHC: 1:50-1:200
ICC/IF: 1:50-1:200
FC: 1:50-1:100
图片:

Western blot analysis of HDAC2 on different lysates using anti-HDAC2 antibody at 1/1,000 dilution. Positive control:
Lane 1: 293T
Lane 2: K562
,

Immunohistochemical analysis of paraffin-embedded rat spinal cord tissue using anti-HDAC2 antibody. Counter stained with hematoxylin.
,

Immunohistochemical analysis of paraffin-embedded human tonsil tissue using anti-HDAC2 antibody. Counter stained with hematoxylin.
,

Immunohistochemical analysis of paraffin-embedded human breast carcinoma tissue using anti-HDAC2 antibody. Counter stained with hematoxylin.
,

Immunohistochemical analysis of paraffin-embedded mouse spinal cord tissue using anti-HDAC2 antibody. Counter stained with hematoxylin.
,
ICC staining HDAC2 in Hela cells (green). The nuclear counter stain is DAPI (blue). Cells were fixed in paraformaldehyde, permeabilised with 0.25% Triton X100/PBS.
,

ICC staining HDAC2 in SHG-44 cells (green). The nuclear counter stain is DAPI (blue). Cells were fixed in paraformaldehyde, permeabilised with 0.25% Triton X100/PBS.
,

ICC staining HDAC2 in 293 cells (green). The nuclear counter stain is DAPI (blue). Cells were fixed in paraformaldehyde, permeabilised with 0.25% Triton X100/PBS.
,

Flow cytometric analysis of Hela cells with HDAC2 antibody at 1/50 dilution (red) compared with an unlabelled control (cells without incubation with primary antibody; black). Alexa Fluor 488-conjugated goat anti rabbit IgG was used as the secondary antibody.
风险提示:丁香通仅作为第三方平台,为商家信息发布提供平台空间。用户咨询产品时请注意保护个人信息及财产安全,合理判断,谨慎选购商品,商家和用户对交易行为负责。对于医疗器械类产品,请先查证核实企业经营资质和医疗器械产品注册证情况。
文献和实验:使用 Anti-phospho-Akt (Ser473) Rabbit mAb 对石蜡包埋的人乳腺癌组织进行免疫组织化学分析。(图 A)使用免疫组化试剂盒M&R HRP/DAB Detection IHC Kit,抗体 1:100 稀释;(图 B) 采用普通免疫组化试剂盒,抗体 1:25 稀释。 图 6 免疫组化实验检测 Erk1/2 表达 注:使用 Anti-Erk1/2 Mouse mAb与p44/42 MAPK (Erk1/2)Rabbit mAb 对正常小鼠心脏组织进行免疫
h)即可。2. 修复大法——不仅仅是「煮一煮」微波炉修复:简单易行效果好,CST 推荐使用微波炉完成修复。合适的修复液:根据抗体说明书使用合适的修复液。用柠檬酸修复后,切片需浸泡在修复液中,自然冷却;而用 EDTA 修复后,切片可直接从修复缸中取出,直接进行下一步。注:使用不同的修复方式和不同生产商的抗体检测人肺癌组织中 EGFR 的表达。第一排为 CST 的 EGF Receptor (D38B1) XP® Rabbit mAb(#4267),EDTA 的修复方式明显优于柠檬酸盐及胃蛋白
到 PVDF 膜上,同时减少蛋白不必要降解,这对于最终获得清晰、可信结果也是需要考虑因素。抗体信息:1.ACC1, Recombinant Rabbit monoclonal IgG. HuaAn. HuaAn biotechnology , inc.2.ATGL, Mouse mAb IgG1, Cat#:RT1058. HuaAn biotechnology , inc.3.p-PERK(Thr981), Rabbit Polyclonal IgG primary antibodies, Cat
技术资料暂无技术资料 索取技术资料





![Bcl-2 Rabbit mAb[49367]](https://img1.dxycdn.com/p/s14/2025/0923/496/0462304380155040791.jpg!wh200)
![Stromelysin-1 Polyclonal Antibody[42486]](https://img1.dxycdn.com/p/s14/2025/0922/568/0046652811090600791.jpg!wh200)
![CSE1L Polyclonal Antibody[31718]](https://img1.dxycdn.com/p/s14/2025/0923/305/2150219664296040791.jpg!wh200)
![REN Conjugated Antibody[C32327]](https://img1.dxycdn.com/p/s14/2025/0923/278/4431488150116040791.jpg!wh200)
